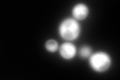
YJR104C
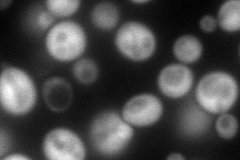
YJR104C
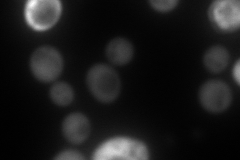
YJR104C
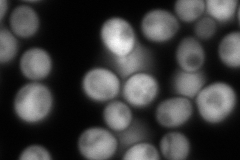
YJR104C
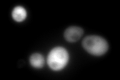
YJR104C
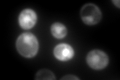
YJR104C

View description
Cytosolic copper-zinc superoxide dismutase; some mutations are analogous to those that cause ALS (amyotrophic lateral sclerosis) in humans
Localization:
Intensity:
Fold change:
Significance:
-
C’ GFP library in SD
cytosol852.31 -
N' NOP1pr-GFP in SD
cytosol220.971 -
N' TEF2pr-mCherry in SD
nuclear periphery0 -
N' NATIVEpr-GFP in SD
cytosol432.082 -
N' TEF2pr-VC and Cyto-VN in SD

#N/A0 -
C’ GFP library in SD+DTT
cytosol952.371.11No -
C’ GFP library in SD+H2O2

cytosol651.160.76No -
C’ GFP library in Starvation Media
cytosol1013.751.18No -
C’ GFP library on the background of Pup2-DaMP

cytosol -
C’ GFP library on the background of CCT mutant

cytosol738.9040.866933No
